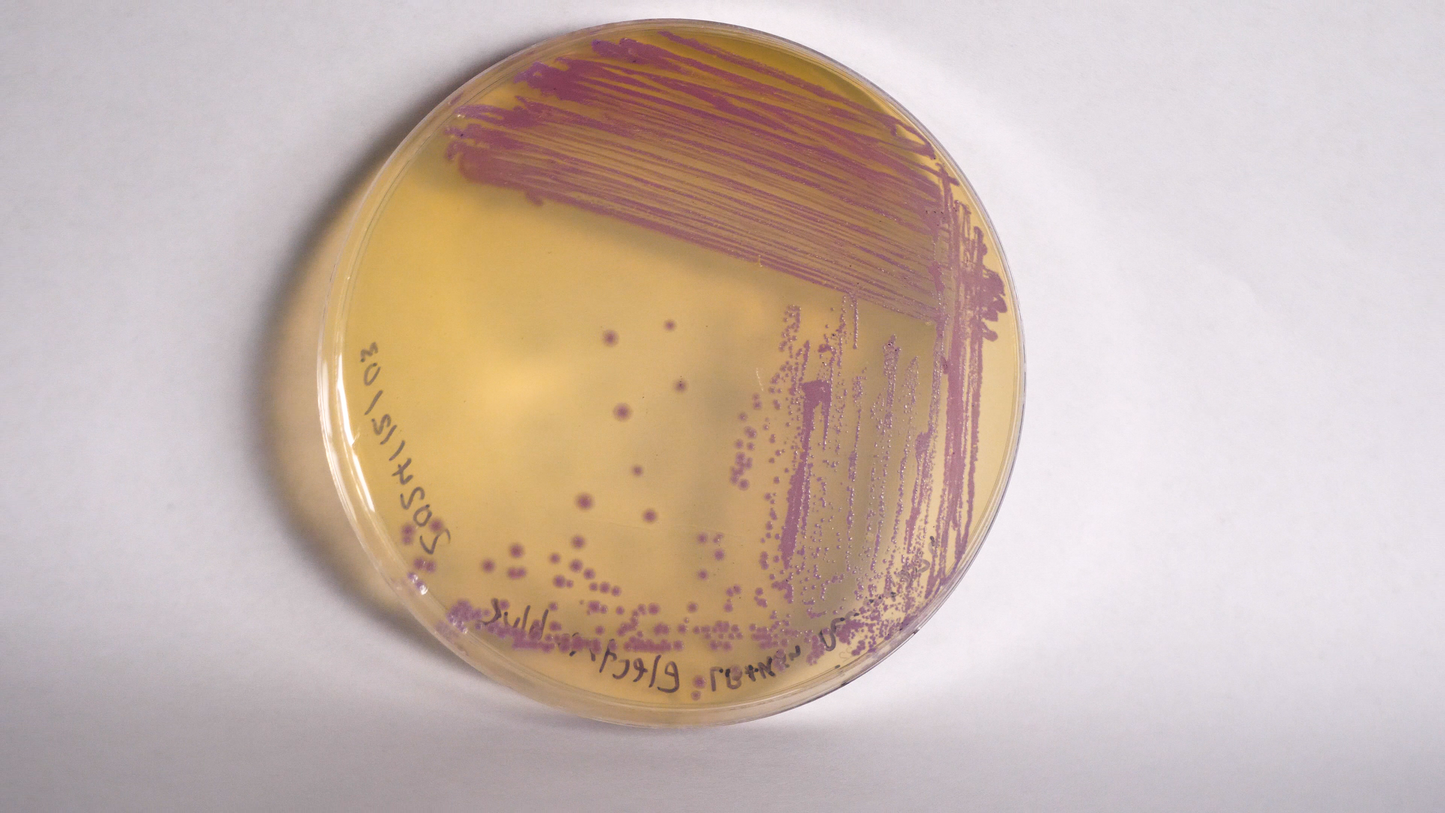

The Thought Emporium
Electric blue | Plasmid
Electric blue | Plasmid
Couldn't load pickup availability
This plasmid contains our home made true blue protein called “electric blue”. Electric blue is a fusion of 2 fluorescent/chromoproteins: amilCP and Electra2. The former contributes a deep blue purple shade in white light, while the former contributes it’s ultramarine fluorescent glow under UV.
The plasmid is designed so that you can easily pop the protein out and transplant it into your own constructs and use it as a reporter. Or just use it for some beautiful agar art.
The plasmid is based on pet9a, and as such uses kanamycin as the resistance marker, and is low copy. The DNA is provided as 10ug of freeze dried DNA and must be shipped express. Freeze and store at -20C on receipt.
Plasmid maps can be found on our github: HERE
These constructs are provided as open source for you to modify and use as you please. Though we do ask for attribution, and no direct commercial resale.
Share